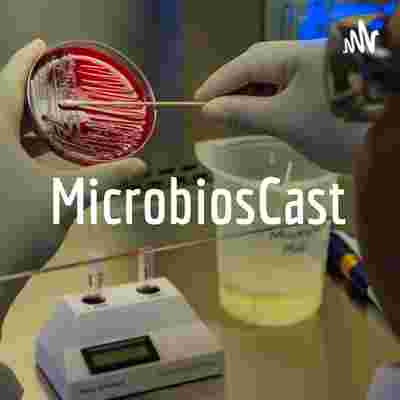
https://d3t3ozftmdmh3i.cloudfront.net/production/podcast_uploaded400/16057127/16057127-1623951656269-5e6dee187ded7.jpg

O Microbioscast, vinculado ao projeto de extensão Superbug.UnB, tem o compromisso de trazer ciência aos ouvidos sedentos por conhecimento. Neste episódio os estudantes do curso de Farmácia/FS/UNB trazem uma conversa bem esclarecida sobre uma doença ainda muito negligenciada, embora seja de impactante endemicidade no Brasil. A Doença de Chagas tem um marcante histórico no país, pois foi aqui que seu ciclo foi desvendado por um cientista brasileiro, Carlos Chagas. Este episódio está "recheado" de ciência, história, informações importantes, e claro, aquela "pegada" típica dos nossos Podcasts, linguagem simples, mas sem perder a ciência por trás.
Créditos:
-Larissa Oliveira Lopes;
-Matheus Sevilha;
-Luís Eduardo;
-Luana Rossi;
-Edmilson Júnior;
- Laís Siqueira de Jesus
- Mayara Silva
- Ellen Monteiro
- Leonardo Matheus
* Disciplina Fundamentos de Parasitologia - Turma 2/2021
Supervisão: Profa. Dra. Fabiana Brandão - Departamento de Farmácia/UnB.